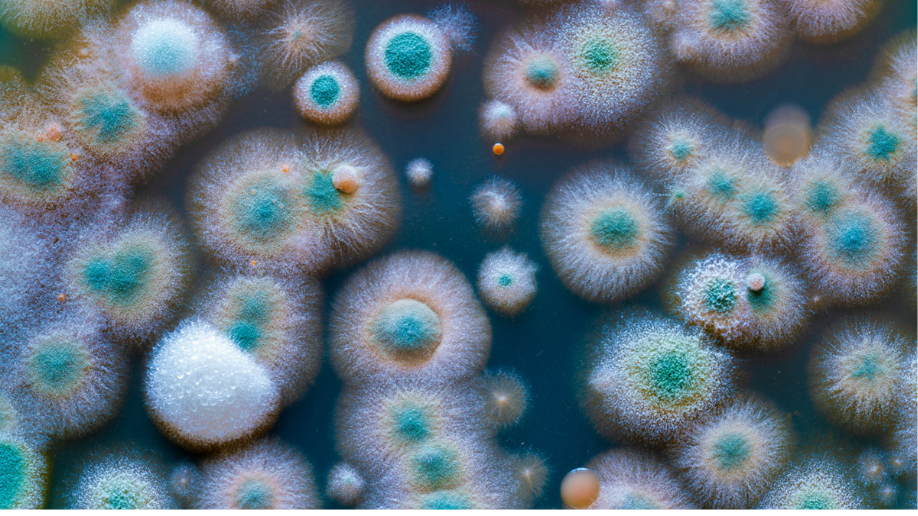

Las 7 Herramientas de Calidad
Autor: actioglobal.com

Estudiada desde los años 50, la calidad ha sido uno de los focos principales de cualquier compañía debido al impacto que podía generar entregar un producto o un servicio fuera de las especificaciones marcadas o esperadas por el cliente.
Hablar de calidad, es hablar de calidad interna, o aquella que evalúa las desviaciones obtenidas de las operaciones internas, pero calidad también es hablar de calidad externa, aquella evaluada desde el mismo cliente.
En el caso de calidad interna, es fácil encontrar medidas como el "% Rechazo interno" o el "Número de defectos del proceso"; mientras que hablar de calidad externa, significa medir la calidad en términos de "Satisfacción del cliente", "Número de Quejas y Reclamaciones" o "Número de devoluciones".
Independientemente del tipo de calidad y de cómo la midamos, lo que es indiscutible es que la No Calidad tiene un coste, bien sea por el reproceso que genera, bien sea por lo que implica todo el proceso de devolución o bien sea por la materia prima que has empleado y que finalmente, has tenido que tirar.
Industria Alimentaria Academy, Organiza el Curso Especializado - Taller: Herramientas de Calidad y Control de los Procesos en la Industria
Gestión de la Calidad
La cuestión a tratar es clara, ¿cómo logramos reducir la No Calidad de nuestros procesos y productos?
La respuesta a la pregunta pasa por utilizar una serie de herramientas, que aplicadas todas ellas sobre los procesos, permiten un análisis y mejora de la misma. Todas estas metodologías, se conocen como "Las 7 Herramientas de la Calidad".
Las 7 Herramientas de la calidad son:
- Diagramas de Causa – Efecto
- Planillas de inspección
- Gráficos de control
- Diagramas de flujo
- Histogramas
- Gráficos de Pareto
- Diagramas de dispersión
1. Diagrama de Causa-Efecto
El ‘Diagrama de Ishikawa’, también conocido como ‘Diagrama Causa-Efecto’, Fishbone Diagram, Diagrama de Espina de Pez o Diagrama de las 6M, es una representación gráfica de todas las causas que generan un problema.

Quizás una de las más importantes, conocidas y empleadas para la gestión de la calidad, esta representación gráfica es clara y simple y simplifica de manera visual todas las causas desembocan en un eje principal que representa el problema en cuestión a estudiar.
Tal y como refleja el Diagrama de causa-efecto, o Diagrama de Ishikawa, las causas a un problema pueden englobarse en 6 categorías diferentes, todas con la primera letra ‘M’, de ahí el otro nombre, Diagrama de las 6M.
2. Plantillas de inspección
Las "plantillas de inspección" son una herramienta útil para la recogida y registro de la información. De algún modo, dicha herramienta debe permitir recolectar datos de un proceso para después poder tomar decisiones sobre dónde y cómo actuar.

3. Gráficos de Control
Los "Gráficos de Control" son representaciones gráficas útiles para conocer, estudiar, analizar y mantener bajo control a lo largo del tiempo la variabilidad de un proceso.
Empleando unos límites de control, tales como LCS (Límte de Control Superior) y LCI (Límte de Control Inferior) que derivan de las tolerancias deseadas para el proceso controlado, es fácil y visual interpretar cuando el proceso está desviado.

4. Diagramas de flujo
Los "Diagramas de flujo" son la herramienta de representación visual de los procesos de la organización y de las actividades desempeñadas por la empresa para producir un output, producto o servicio determinado para un cliente.
Como herramientas de calidad, los Diagramas de flujo facilitan la comprensión de qué estamos haciendo y cómo estamos desempeñando el trabajo y, por tanto, favorecen la comprensión del entorno.

Industria Alimentaria Academy, Organiza el Curso Especializado - Taller: Herramientas de Calidad y Control de los Procesos en la Industria
Si desea conocer más sobre las herramientas de control de calidad dentro del sector, inscíbase en nuestro curso HERRAMIENTAS DE CALIDAD Y CONTROL DE LOS PROCESOS EN LA INDUSTRIA ALIMENTARIA. Conozca y aplique las técnicas y herramientas que permitan resolver problemas de calidad para mejorar los procesos en la industria. Asimismo, analizar correctamente los datos obtenidos para la toma de decisiones en su organización.
5. Histogramas
Otra de las 7 Herramientas de la calidad ampliamente utilizada, son los "Histogramas". Un Histograma es la representación gráfica de una distribución en clases de una variable continua. La altura de cada una de las columnas representa la frecuencia de repetición de los valores.

Con tal representación visual, es fácil poder determinar cuál es el patrón de comportamiento de una muestra tomada y cuáles son los resultamos de dicha muestra, en términos de tendencia central y variación.
6. Gráficos de Pareto
La penúltima de las 7 herramientas de la calidad, son los ‘Gráficos de Pareto’. Vilfredo Pareto fue un sociólogo italiano, ingeniero, economista y filósofo, cuyos estudios de sociología en Italia determinaron que el 20% de la población italiana poseía el 80% de las tierras italianas, mientras que el 80% de población restante, poseía solamente el 20% delas tierras que quedaban.
De esta manera Pareto, y ligando con la calidad de un proceso, ideó lo que hoy conocemos como Principio de Pareto, Ley de Pareto o regla del 80-20, a partir de la cual podemos representar visualmente cómo el 80% de los rechazos de un proceso son debidos a un 20% de causas.

7. Diagramas de Dispersión
Por último, la séptima herramienta de la calidad, son los "Diagramas de dispersión", herramienta útil para comprender la relación existente entre dos variables, una variable que se representa sobre el eje X, mientras que otra variable se representa en el eje Y. De esta manera es fácil poder comprender la correlación entre dos variables y cómo, cuando varía el valor de una de ellas, varia el valor de la otra.

Todas y cada una de las anteriores herramientas comentadas, son empleadas en las metodologías de Lean Six Sigma como herramientas que permiten conocer y analizar la calidad de un proceso para después tratar las no conformidades.
No debemos olvidar que, para conseguir mejorar procesos de negocio, es primordial en primera instancia, capacitar a las personas que trabajan en ello sobre la herramientas y metodologías existentes. Solamente si éstas personas conocen las herramientas, serán capaces de mejorar su entorno.
Fuente: actioglobal.com

_Mesa de trabajo 1.png)
.jpg)

.png)

_Mesa de trabajo 1 (1).png)
.gif)
.gif)

-423-x-356-px.jpg)
.jpg)


























.png)











.png)





















.jpg)

.png)

.png)
.png)























003.png)





















































